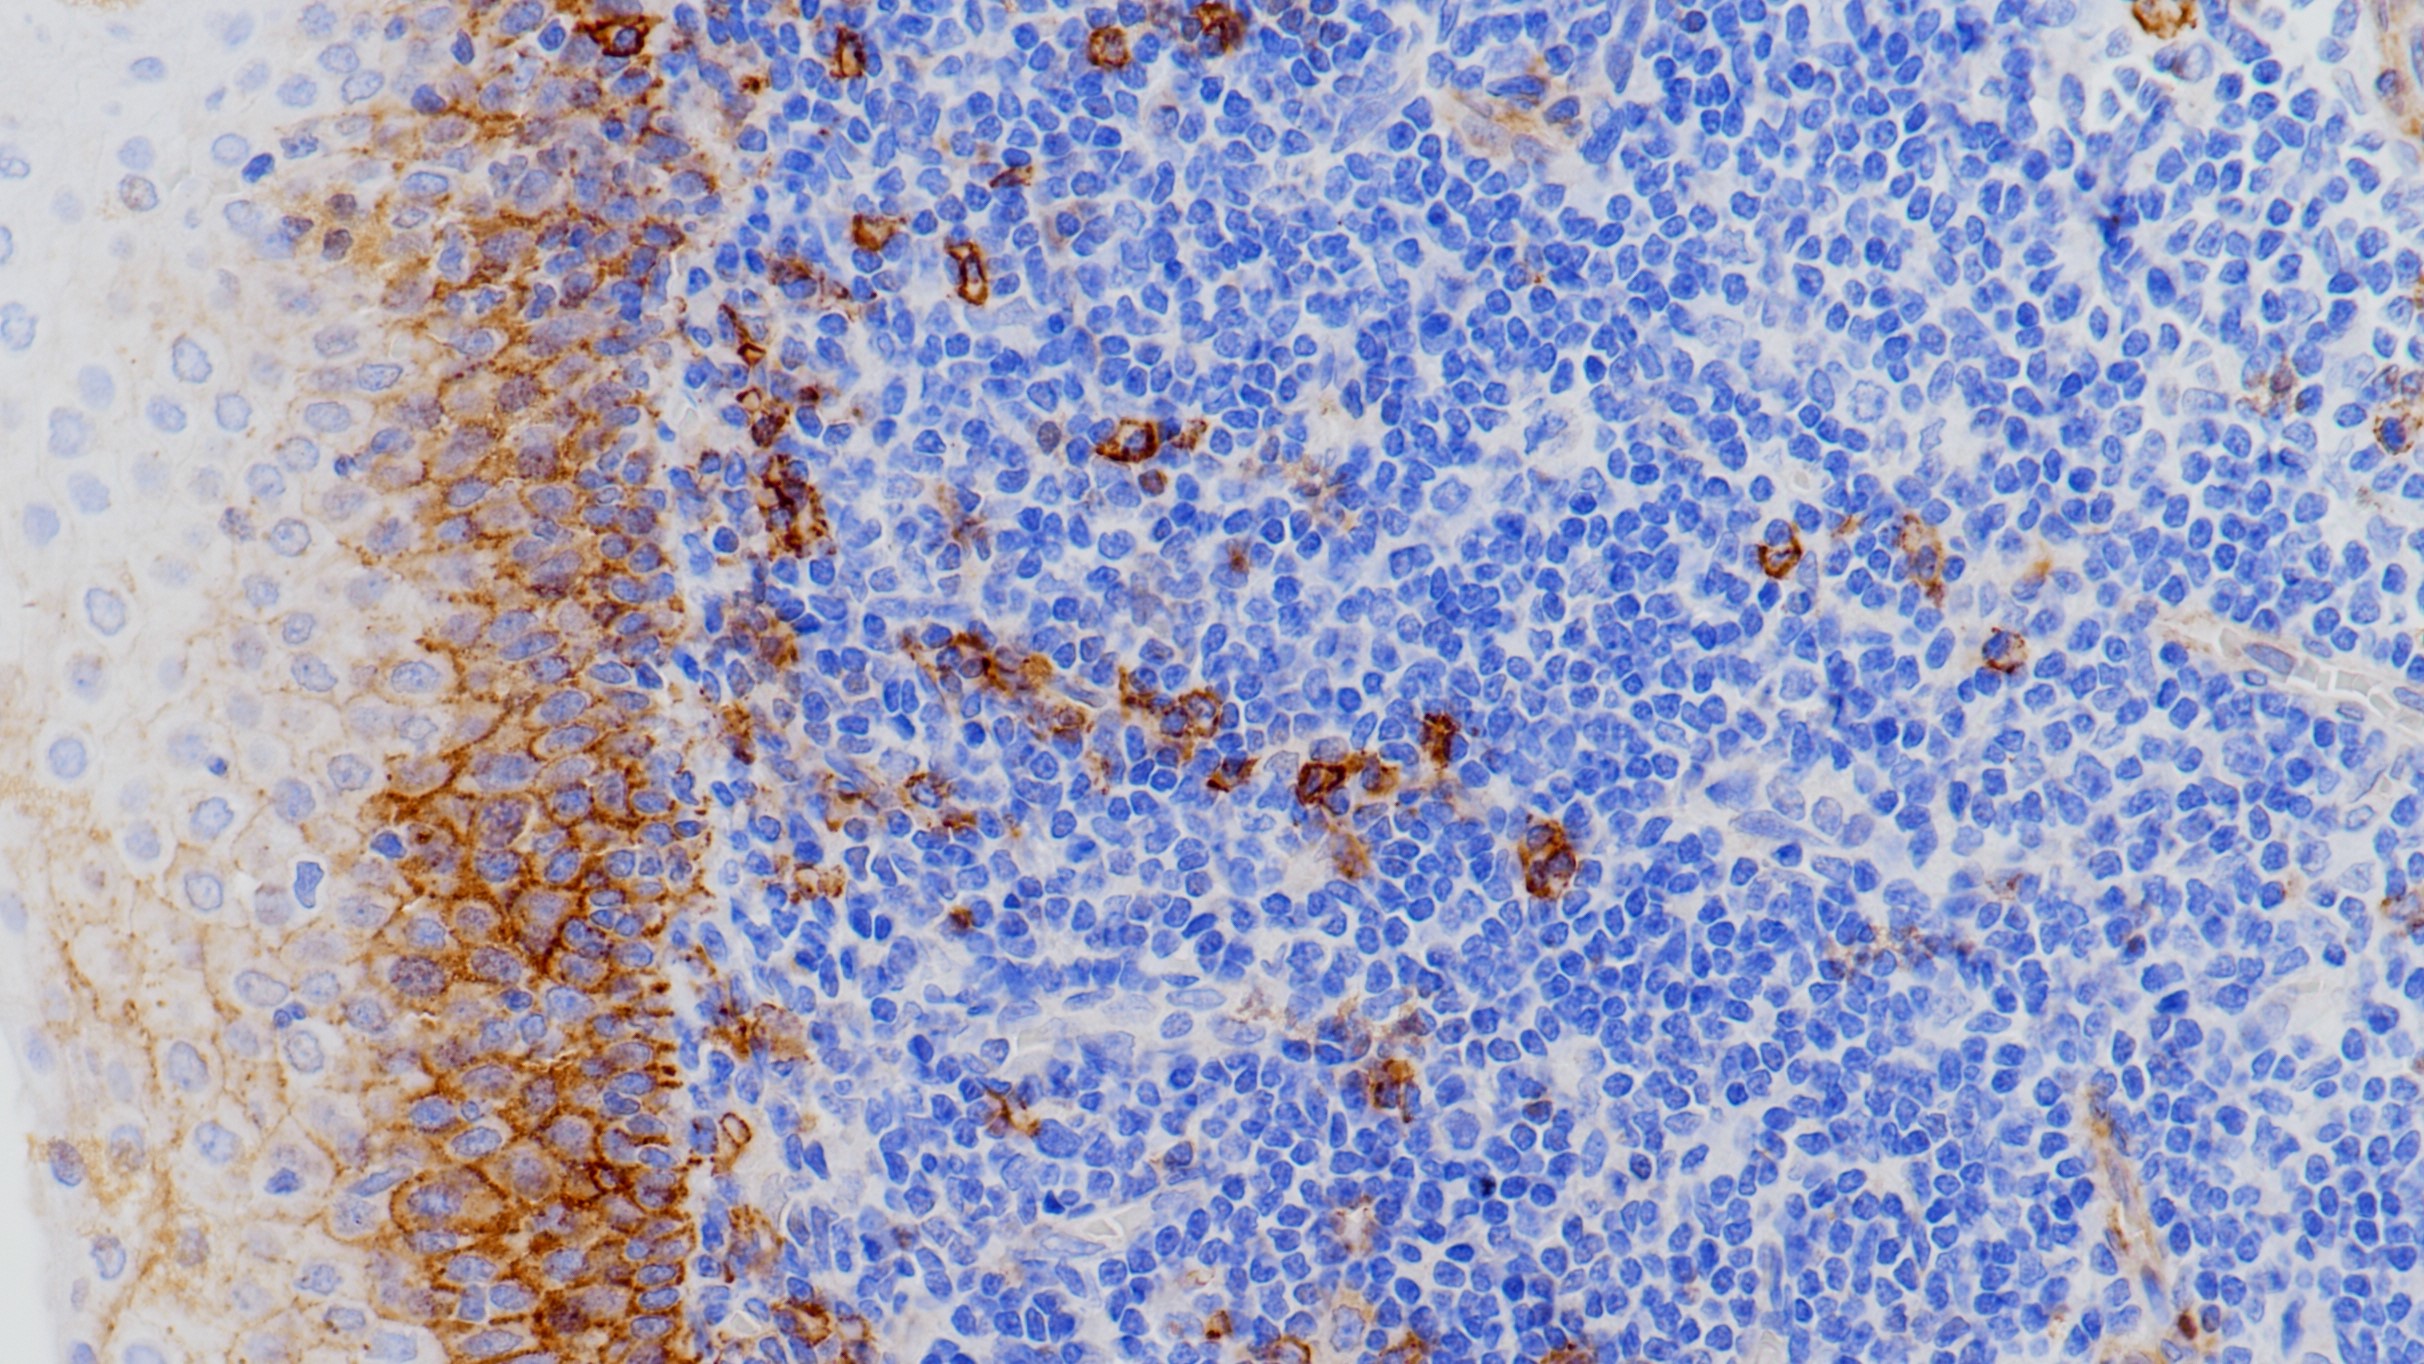
扁桃体CD138(BP6035)染色

1. Mohamed A, et al. SOX10 Expression in malignant melanoma, carcinoma, and normal tissues. Appl Immunohistochem Mol Morphol. 2013 Dec; 21(6):506-10.
2. Mollaaghababa R, Pavan WJ. The importance of having your SOX on: role of SOX10 in the development of neural crest-derived melanocytes and glia. Oncogene. 2003 May 19; 22(20):3024-34.
3. 中华医学会.《临床技术操作规范·病理学分册》.人民军医出版社,2004.